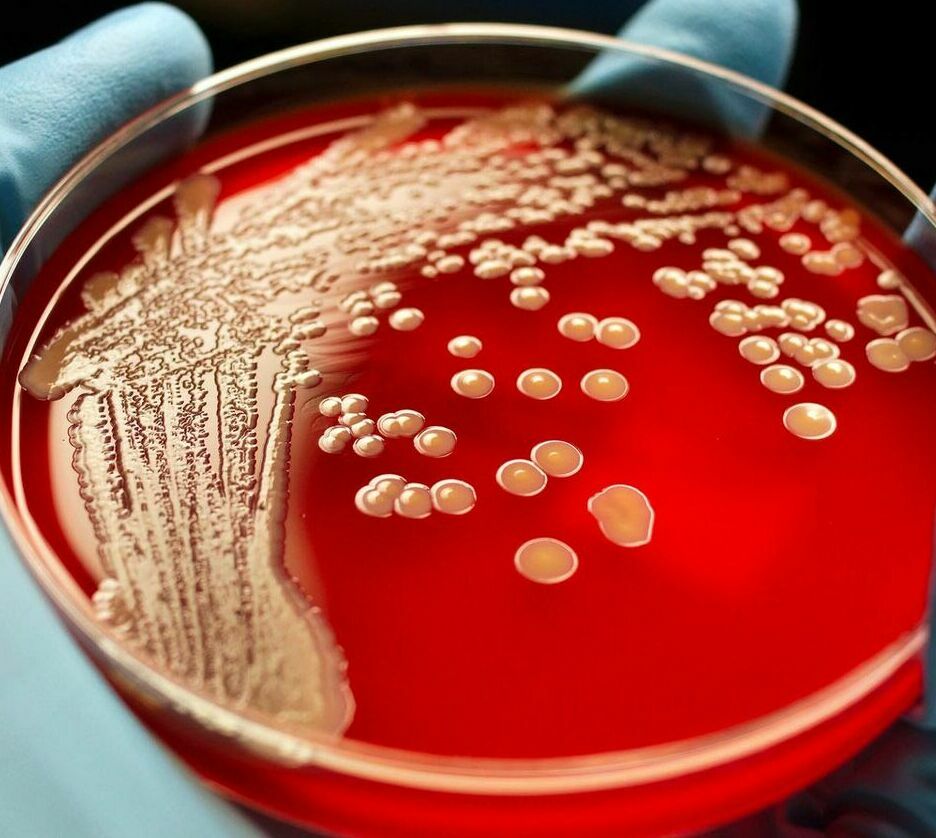

Направления лечения
Все медицинские услуги для детей в одной клинике
Каждый день принимают педиатры и узкие специалисты, поэтому всех необходимых детских врачей можно пройти сразу. В отделении педиатрии посетителей ждут мультики и игровая зона, чтобы дети чувствовали себя спокойно
Запись на прием
О медицинском центре
Дорогие посетители, мы рады приветствовать Вас на сайте нашей компании. В 2012 году Лор-Центр открыл свои двери для первых пациентов на улице Тельмана в городе Тамбове. В 2019 году мы переехали на улицу Советская 85а для расширения спектра наших услуг. Комфорт и забота о пациентах, оказание им квалифицированной медицинская помощь является приоритетами нашего медицинского центра. За 11 лет нашей работы более 12 тысяч пациентов доверили нам свое здоровье, Спасибо за Ваш выбор.

Медицинский центр Лор+
Профессиональное развитие
Повышение квалификации каждого сотрудника ежегодно
Индивидуальный подход
Мы учитываем личностные особенности каждого пациента
Безопасность лечения
Строгий инфекционный контроль и тщательная очистка инструментария
Адрес клиники:
- г. Тамбов, ул. Советская 85а
- с 08:00 до 15:00, Выходной воскресенье
Информация о сайте:
Мы в Instagram
Пока нет фото или видео!
Привяжите аккаунт, чтобы показывать фото